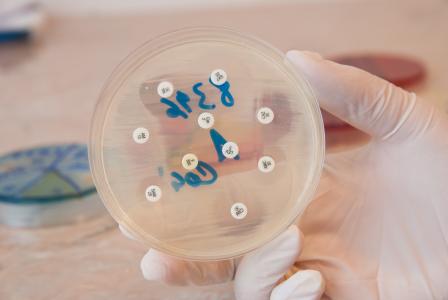
C'est l'espoir l’espoir du développement d’un vaccin contre l’infection à Campylobacter jejuni, une bactérie responsable d'entérite et de septicémie parfois (Visuel Adobe Stock 95277279)

ENTÉRITE, SEPTICÉMIE, INTOXICATION : Un vaccin contre Campylobacter ?
Ces travaux d’une équipe de biologistes de l’Université d’Osaka donnent l’espoir du développement d’un vaccin contre l’infection à Campylobacter jejuni, une bactérie responsable d'entérite et de septicémie parfois, en particulier chez les enfants de moins de 5 ans et les personnes âgées, avec des dizaines de milliers de décès à la clé. Cette découverte d’un anticorps spécifique à Campylobacter jejuni, qui inhibe la croissance et la pathogénicité des bactéries, est documentée dans la revue Frontiers in Microbiology.
Campylobacter jejuni est une bactérie en forme de bâtonnet en spirale, et l’un des principaux responsables de la mortalité infectieuse diarrhéique et extra-intestinale chez les enfants, ce qui en fait une priorité de santé mondiale. D’autant qu’il n'existe pas de vaccin ou de médicament efficace contre C. jejuni.
Une étape clé vers la prévention, le diagnostic et le traitement contre l'infection à Campylobacter
- L’étude identifie la molécule QcrC dans plusieurs souches de C. jejuni, cette molécule, un complexe multiprotéique étant essentielle à la production d’énergie de C. jejuni, à la croissance de la bactérie et sa pathogénicité ;
- retrouvé dans de nombreuses souches, ce complexe semble extrêmement stable pour identifier et cibler l’espèce bactérienne ;
- à partir d’QcrC l’équipe développe un anticorps monoclonal à la fois capable d’identifier C. jejuni et d’inhiber la croissance de la bactérie ;
- l’anticorps monoclonal réagit au complexe multiprotéique QcrC et bloque donc la pathogénicité de la bactérie.
Ces premiers résultats constituent une solide avancée vers des approches préventives permettant de détecter C. jejuni et d’éviter que les infections à Campylobacter ne s’aggravent.
« C’est le développement d’un système de détection simple », ajoute l’un des auteurs principaux, le professeur Yamasaki, microbiologiste, « qui permettra notamment l’identification rapide des aliments contaminés, le contrôle des infections à C. jejuni et des intoxications alimentaires et le développement de vaccins ».
Autres actualités sur le même thème
PARKINSON : La bactérie du microbiote qui pourrait éliminer la maladie
Actualité publiée il y a 1 année 7 moisRGO : Il accroît le risque de cancer de l’œsophage
Actualité publiée il y a 5 années 1 moisMICROBIOTE : Il médie la perméabilité intestinale et la résistance à l’insuline
Actualité publiée il y a 6 années 7 moisPARODONTITE : L’exercice fait bouger les bactéries aussi
Actualité publiée il y a 4 années 12 mois




